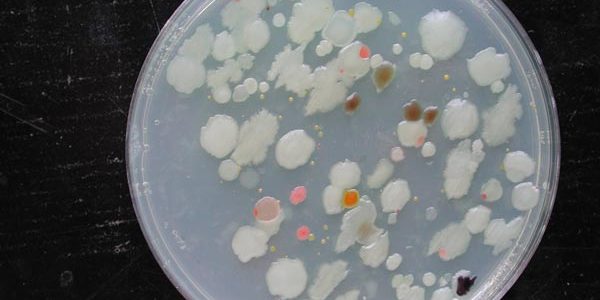

The coffee-machine bacteriome
Microbial communities are ubiquitous in both natural and artificial environments. However, microbial diversity is usually reduced under strong selection pressures, such as those present in habitats rich in recalcitrant or toxic compounds displaying antimicrobial properties. Caffeine is a natural alkaloid present in coffee, tea and soft drinks with well-known antibacterial properties. Here we present the first systematic analysis of coffee machine-associated bacteria. We sampled the coffee waste reservoir of ten different Nespresso machines and conducted a dynamic monitoring of the colonization process in a new machine. Our results reveal the existence of a varied bacterial community in all the machines sampled, and a rapid colonisation process of the coffee leach. The community developed from a pioneering pool of enterobacteria and other opportunistic taxa to a mature but still highly variable microbiome rich in coffee-adapted bacteria. The bacterial communities described here, for the first time, are potential drivers of biotechnologically relevant processes including decaffeination and bioremediation.
More here – Scientific Reports
Long story made short – your home espresso machine is full of bacteria. Hopefully we might see some form of selective mutation that leads to a variation of Pseudomonas which is fatal to hipsters.

This could also have ramifications for the teapot hygiene of grumpy old men.
Thats why they invented the dishwasher.
Long story made short – *everything* is full of bacteria. You could do this same research on anything from your kitchen chux to your shower rose and it would come back with essentially the same results. Except with the shower rose you are swallowing, covering your body with and inhaling the mist of the said bacterial soup (unlike the coffee machine drip tray). Its no big deal – our bodies are 90% foreign bacterium anyway (by cell count).
Hi Drew,
Do you have any information on the bacteriological state of dishwashers – specifically the possible presence of mutating pathogenic Pseudomonades with a teapot progenitor? I am deeply concerned for the well being of someone who might already be very frail.
What does not kill you only makes you stronger. Especially when it comes to bacteria. We live in a much too clean an environment anyway.